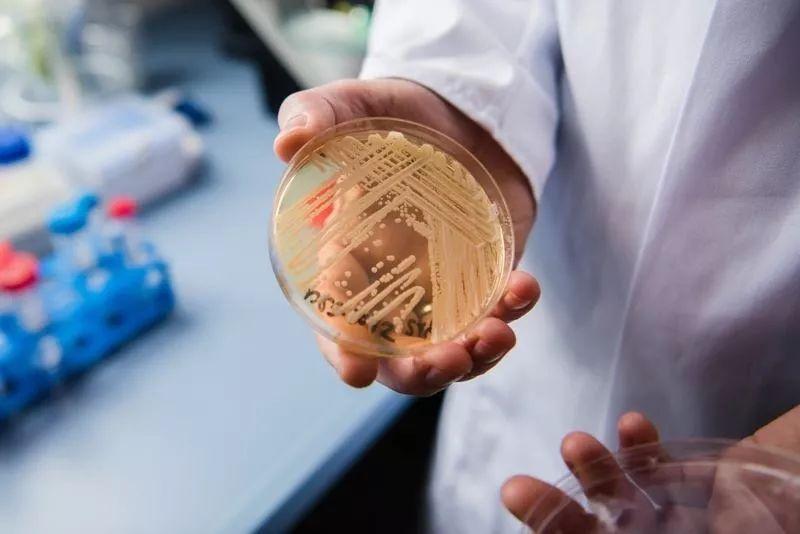

【知识】 被刷屏的“超级真菌”,耳念珠菌真的那么可怕吗?






这几天,一则有关中国确诊18例超级真菌耳念珠菌感染的消息在各种社交媒体上疯狂传播,话题下的文章大同小异,内容又仅限于“威胁”、“超级真菌”、“可怕”等字眼,这几天弄得人心惶惶,却没有一个专业文章来解读。实际上,国内所受到的耳念珠菌威胁并不严重,耳念珠菌在国内发生仍属个案。

小编带大家详细解读
耳念珠菌
是怎么回事
01
耳念珠菌被称为“超级真菌”
不严谨


耳念珠菌于2009年在日本首次发现的一种病原真菌物种;通过对储存的念珠菌进行回顾性检测,最早在1996年的韩国已经出现。
目前,将耳念珠菌称为“超级真菌”并不严谨,耳念珠菌的致病性并未显著高于其它真菌。即使是日本分离出的第一株耳念珠菌,也并没有那么凶险,对多种抗真菌药物均敏感。据欧美和日本等国家的研究表明,耳念珠菌与白念珠菌等常见念珠菌所致感染的死亡率之间无显著差异。中国耳念珠菌耐药情况并不严重,对除氟康唑外的所有抗真菌药物均敏感;我国尚未见耳念珠菌感染导致死亡的病例报道。
02
耳念珠菌确实与众不同

有研究表明,耳念珠菌在潮湿或干燥的表面上能至少生长7天,在塑料表面可持续存活至少2周。耳念珠菌不仅可以在患者腋窝、腹股沟、鼻、口咽部等多个部位定植,还能在床栏、地板等多种物品表面存活,对共用医疗器械造成污染。这种几乎“全能”型的环境适应能力和长时间存活能力,是耳念珠菌与其它念珠菌的不同之处。
03
耳念珠菌引起的感染与传染病
不一样

与曾经大规模暴发流行的非典、甲型H1N1流感不一样,非典和甲型H1N1流感是由病毒引起的传染病,可以在人-人、人-动物之间传递。耳念珠菌属于侵袭性真菌,引起的是真菌感染,一般发生在医院里,虽然它耐药性强,但致病力并不强。该真菌的感染主要发生在具有严重基础性疾病的长期住院患者中,高风险人群为严重慢性基础病或免疫抑制的病人(如:糖尿病、慢性肾病、HIV感染、肿瘤等);新生儿、插管或留置导管的病人、手术病人以及使用广谱抗生素或抗真菌药全身用药病人也可感染。耳念珠菌主要引起血流、尿路、手术创面等感染。尽管耳念珠菌的致病机制并未被完全阐明,但其致病性与白念珠菌有很多相似的地方,其整体毒力弱于白念珠菌。
国内所受到的耳念珠菌威胁并不严重,耳念珠菌在国内发生仍属个案。中国共报道耳念珠菌感染18例,并且没有集中暴发案例。在中国近10年间、覆盖230家医疗机构的侵袭性真菌病监测中,耳念珠菌的发生率低于1/20000。在已经完成的全国范围67家ICU病房念珠菌血症的研究中,亦未分离到耳念珠菌。“超级真菌”对健康人群不构成威胁,因此公众不必恐慌。
但是,免疫力低下的老年人、新生儿、糖尿病患者、重症监护室患者及术后患者等容易感染。因此,人群密集的医疗机构、养老机构等,应该充分引起重视。
04
就算“超级耐药”也是有办法
清除的

资料显示,目前该真菌主要对氟康唑耐药,对其它抗真菌药的耐药性在不同菌株间存在差异,大部分耳念珠菌感染病例可使用棘白菌素类抗真菌药治疗。即使是对于多重耐药耳念珠菌感染病例,仍有希望通过提高抗真菌药物的剂量或联合用药达到治疗的效果。
05
耳念珠菌感染并非不可预防

健康人通常不会感染耳念珠菌。对于普通健康人群而言,耳念珠菌并没有什么影响,也不需要特殊预防。该真菌在普通环境或空气中几乎从未检出,但是它黏附能力很强,会顽固地黏附在环境表面,可以明确的是,感染主要发生在医院内,集中在免疫力低下的人群,如重症监护病房。因此,医疗器械如呼吸机、血透留置导管等接口处的清洁十分重要,必须做好充分的消毒。
“超级真菌”主要通过接触病人以及接触被病人污染过的物体表面传播。从预防的角度来看,勤洗手和彻底清洁院内物品是阻断“超级真菌”传播的重要手段。所以,患者的家属以及和患者密切接触的人,在接触病人或病人接触过的物体前后要彻底洗手。

供稿:委疾控处


还没有内容